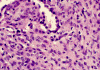
Com309-1-HM1.gif (121458 bytes)

| A 55 year-old Woman with a
Well-defined Round Lesion in the Lung. September, 2003, Case 309-1. Home Page |
Charuhas
G. Deshpande
Department of Pathology, University of Oklahoma Health Science Center, Oklahoma City, OK
Clinical information:
The patient was a 55 year-old woman. A well-defined round lesion in the lung that was discovered on routine chest X-ray. The resection yielded the following specimen.
Pathology of the case:
 |
 |
|
 |
 |
| A. | B. | C. | D. | E. |
Panel A shows features of the periphery of the tumor that interfaces with the non-neoplastic lung parenchyma. Many choloesterol clefts are present and probably due to resolved hemorrhage. Panel B shows the periphery of the tumor which gives a papillary type of architecture although a real fibrovascular core is absent. Panel C shows the details of these areas. The lesional tissue appear to be composed of solid sheets of mononuclear cells with amphophilic cytoplasm. The cell border is quite clear in some areas but no intercellular bridges or keratinization is present. The surface of the solidly packed cells are lined by a single layer of cuboidal mononuclear cells. The papillary-like structures that are typically seen in the periphery transform into solidly packed tumor cells at the center of the lesion as illustrated in Panel D. Sclerotic changes is also present at the center of the lesion as illustrated in Panel E.
| DIAGNOSIS: Sclerosing hemangioma. |
Discussion: General Information Pathology Differential diagnosis Pathogenesis
General Information
Sclerosing hemangioma was first described by Liebow and Hubell
1.
They
represent about 22.2% - 32.8% of all benign pulmonary tumors
2.
There is a definitive female preponderance with a male to female ratio in
the range of 1:4 to 1:15. The age range is also wide and spans from 13-78 years
3,
4,
5.
The majority of sclerosing hemangiomas are incidental findings on routine chest
x-ray examination. When sclerosing hemangioma manifests, the symptoms include
recurrent chest pain, cough, hemoptysis and rarely as exertional dyspnea
3,
6,
7.
Although sclerosing hemangioma often occurs as a solitary mass, there are
cases with multiple nodules, mediastinal mass and lymph node metastases with no
effect on prognosis
8,
9,
10,
11,
12.
Extracapsular enucleation is the treatment of choice for sclerosing hemangiomas
13.
On plain film, sclerosing hemangioma occurs as solitary central,
intraparenchymal or peripherally located, pleural-based lesion with as
well-defined homogeneous, round to oval shadow on chest roentgenograms
3.
Sclerosing hemangioma appears as homogeneous mass on CT scan. A hypodense
portion would be seen if cystic changes are present. On MRI scan, they appear as
lesions with mixed areas of high- and low-signal intensity on both T1- and
T2-weighted images that demonstrate postcontrast
2,
14.
Macroscopically, sclerosing hemangiomas are usually small, solitary nodules with
a mean diameter of about 2.5 cm and the range is 0.3 to 7.0 cm
3,
5,
6,
15.
The margin is well defined and the cut surface is variegated gray to tan-yellow.
Cystic changes, focal hemorrhage, and calcifications may be present.
Microscopically, sclerosing hemangiomas
have two salient histologic features: marked proliferation of sclerotic, small
blood vessels and dual population of mononuclear cells with pale or eosinophilic
cytoplasm and pnemocyte-like cuboidal cells. The interplay of these two components generates four recognizable
patterns, namely, papillary, solid, hemorrhagic, and sclerotic.
The sclerotic pattern does not usually occur as a pure pattern but
accompanies the three patterns. The center of the tumors tends to be more
sclerotic. In the sclerotic areas, the collagen is dense and the tumor cells are
sparse. In the papillary tumor, the periphery of the tumor has papillary
structures lined by eosinophilic cuboidal cells that resemble the alveolar
pneumocytes. These cells may continue with the surrounding non-neoplastic
alveolar lining cells. There is often a transition of papillary pattern to broad
areas of medium-sized, round or polygonal cells with pale eosinophilic or clear
cytoplasm. The nuclei are usually oval, with fine chromatin and occasional
nucleoli. The solid pattern is composed predominantly of solidly packed tumor
cells without significant papillary component. The hemorrhagic pattern appears
hemangioma-like and is associated with hemorrhage. A mixed pattern is seen in
most sclerosing hemangiomas. Histologic changes secondary to the hemorrhage
including hemosiderin-laden histiocytes, cholesterol clefts, and calcifications
are common. Presence of tumorlets, areas with neuroendocrine features and foci
of mucin production have been described as accompanying findings. The
histological features are usually specific enough to allow rapid diagnosis.
Cytologic diagnosis of sclerosing hemangioma on fine needle aspiration requires
the identification of the dual cell population, specifically the cuboidal
pneumocyte-like cells and the solid sheets of cells
16.
A diagnosis of pulmonary sclerosing hemangioma can be made at intra-operative
frozen sections in most cases. When only a single histological pattern is
identified or when there is significant cytological atypia, distinction from
other tumors can be problematic, and the diagnosis is best deferred
17.
The
immunohistochemical profile of sclerosing hemangioma has been extensively
studied. The consistent positive
immunoreactivity for epithelial membrane antigen (EMA) in both the epithelial
cells and solid sheets of cells, favors the notion that the tumor cells of
sclerosing hemangioma are epithelial, and the strong thyroid transcription
factor-1 (TTF-1) immunoreactivity suggests differentiation toward pulmonary
epithelium
3,
4,
15,
18,
19,
20,
21,
22,
23,
24.
The papillary lining cells expressing EMA as well as PE10 or CAM 5.2 likely
represent entrapped metaplastic alveolar epithelium, whereas the papillary
lining cells expressing only EMA more likely constitute true neoplastic cells
similar to those in the solid areas
24.
Neuroendocrine differentiation of sclerosing hemangioma has been
suggested recently by Xu et al
5.
Differential diagnosis
Inspite of the disagreement about its histogenesis, the histological appearance
is sufficiently specific to make the diagnosis apparent. In the past it was confused with the inflammatory pseudotumor,
a lesion comprised of plasma cells, histiocytes and fibroblasts, with an
inconspicuous vascularity and no papillary proliferation.
The focal areas of sclerosis may produce a disturbing appearance, but the
mixture of elements present is not seen in metastatic papillary carcinomas or in
other pulmonary tumors.
Sclerosing hemangioma has been called historically as histiocytoma, xanthoma,
pneumocytoma, benign sclerosing pneumocytoma or papillary pneumocytoma
1,
25,
26.
Although it has morphological features of a sclerosing tumor of vascular origin,
hence the name sclerosing hemangioma, the histogenic origin remains uncertain.
Epithelial, neuroendocrine, endothelial, mesothelial, histiocytic,
bronchioloalveolar, and nonendothelial mesenchymal origins have been implicated
by various studies to date. In fact, current evidence heavily favors an
epithelial origin over an endothelial or mesothelial origin
1,
2,
3,
4,
5,
10,
27,
28.
Confusion arises as of whether the surface epithelial cells lining the
papillary cores or the cells within the core, so-called stromal or lesional
cells, are the neoplastic cells.
Presence of entrapped normal alveolar lining cells and presence of
tumorlets or carcinoid-like features adds up to the pre-existing debate.
Using the human androgen receptor (HUMARA) gene or the phosphoglycerate
kinase (PGK) gene as X-chromosome-linked polymorphic markers, Niho et al. (1998)
have shown monoclonal origin of both the pale cells as well as the cuboidal
cells after micro-dissecting them, proving that both cellular components are
neoplastic
29.
Ultrastructural studies revealed unequivocal epithelial cells in both the
irregular spaces and the solid areas of the tumor; some of these cells were
identical to granular pneumonocytes. The true vascular component was sparsely
distributed, suggesting that the term, "sclerosing hemangioma" was a
misnomer, rather being an essentially epithelial lesion
26,
30.
Satoh et al. using immunohistochemistry and immunoelectron microscopy
techniques demonstrated that the cytoplasm of some of the sclerosing hemangioma
tumor cells was positive for the anti-lung surfactant apoprotein monoclonal
antibody (PE-10). These cells were the pale cells of the solid areas, the cells
covering the papillary projections, and the cells lining the cleft-like spaces.
These cells also were positive for conventional epithelial cell markers. Some
cells also were positive for vimentin. Electron microscopic study showed that
the predominant cell was a poorly differentiated pneumocyte. Immunoelectron
microscopic study also demonstrated that PE-10 existed in the rough endoplasmic
reticulum of some of the cells in the solid areas, in the same way as normal
type II pneumocytes. These authors concluded that the sclerosing hemangioma is
an epithelial tumor with differentiation towards type II pneumocytes
18.
Reference:
Liebow
A, Hubbell B. Sclerosing hemangioma (histiocytoma, xanthoma) of
the lung. Cancer 1956;9:53-75
Sugio
K, Yokoyama H, Kaneko S, Ishida T, Sugimachi K.
Sclerosing
hemangioma of the lung: radiographic and pathological study. Ann Thorac Surg. 1992; 53:295-300.
Devouassoux-Shisheboran
M, Hayashi T, Linnoila RI, Koss MN, Travis WD.
A clinicopathologic study of 100 cases of Pulmonary Sclerosing Hemangioma
with immunohistochemical studies: TTF-1 is expressed in both round and
surface cells, suggesting an origin from primitive respiratory epithelium.
Am J Surg Pathol 2000; 24:906-916.
Chan
AC, Chan JK.
Pulmonary sclerosing hemangioma consistently expresses thyroid transcription
factor-1 (TTF-1): a new clue to its histogenesis. Am J Surg Pathol
2000; 24:1531-1536.
Xu
HM, Li WH, Hou N, Zhang SG, Li HF, Wang SQ, Yu ZY, Li ZJ, Zeng MY, Zhu GM..
Neuroendocrine
differentiation in 32 cases of so-called Sclerosing Hemangioma of the lung:
Identified by immunohistochemical and ultrastructural study. Am J Surg
Pathol 1997; 21:1013-1022.
Katzenstein
AL, Gmelich JT, Carrington CB.
Sclerosing hemangioma of the lung: a clinicopathologic study of 51 cases.
Am
J Surg Pathol. 1980; 4:343-56.
Shibata
R, Mukai M, Okada Y, Sakamoto M, Yamauchi T, Kobayashi K.
A
case of sclerosing hemangioma of the lung presenting as a gigantic tumor
occupying the left thoracic cavity. Virchows Arch. 2003; 442:409-11.
Noguchi
M, Kodama T, Morinaga S, Shimosato Y, Saito T, Tsuboi E. Multiple
sclerosing hemangiomas of the lung. Am J Surg Pathol. 1986; 10:429-35.
Miyagawa-Hayashino
A, Tazelaar HD, Langel DJ, Colby TV.
Pulmonary sclerosing hemangioma with lymph node metastases: report of 4
cases. Arch Pathol Lab Med. 2003; 127:321-5.
Spencer
H, Nambu S.
Sclerosing
haemangiomas of the lung. Histopathology. 1986; 10:477-87.
Lee
ST, Lee YC, Hsu CY, Lin CC.
Bilateral
multiple sclerosing hemangiomas of the lung. Chest. 1992; 101:572-3.
Yano
M, Yamakawa Y, Kiriyama M, Hara M, Murase T.
Sclerosing
hemangioma with metastases to multiple nodal stations. Ann Thorac Surg.
2002; 73:981-3.
Mahesh
B, Sheffield E, Forrester-Wood C, Amer K.
Pulmonary
sclerosing hemangiomas: new approach in patients with low cancer risk.
Asian Cardiovasc Thorac Ann. 2003; 11:113-5.
Fujiyoshi
F, Ichinari N, Fukukura Y, Sasaki M, Hiraki Y, Nakajo M.
Sclerosing
hemangioma of the lung: MR findings and correlation with pathological
features. J Comput Assist Tomogr. 1998; 22:1006-8.
Hattori
H.
Sclerosing
haemangioma of the lung is positive for MIB-1 in cell membrane and
cytoplasmic staining pattern. Histopathology. 2002; 40:291-3.
Gal
AA, Nassar VH, Miller JI.
Cytopathologic
diagnosis of pulmonary sclerosing hemangioma. Diagn Cytopathol. 2002;
26:163-6.
Chan
AC, Chan JK.
Can
pulmonary sclerosing haemangioma be accurately diagnosed by intra-operative
frozen section? Histopathology. 2002; 41:392-403.
Satoh
Y, Tsuchiya E, Weng SY, Kitagawa T, Matsubara T, Nakagawa K, Kinoshita I,
Sugano H.
Pulmonary sclerosing hemangioma of the lung. A type II pneumocytoma by
immunohistochemical and immunoelectron microscopic studies. Cancer.
1989; 64:1310-7.
Yousem
SA, Wick MR, Singh G, Katyal SL, Manivel JC, Mills SE, Legier J.
So-called
sclerosing hemangiomas of lung. An immunohistochemical study supporting a
respiratory epithelial origin. Am J Surg Pathol. 1988; 12:582-90.
Leong
AS, Chan KW, Seneviratne HS.
A
morphological and immunohistochemical study of 25 cases of so-called
sclerosing haemangioma of the lung. Histopathology. 1995; 27:121-8.
Alvarez-Fernandez
E, Carretero-Albinana L, Menarguez-Palanca J.
Sclerosing
hemangioma of the lung. An immunohistochemical study of intermediate
filaments and endothelial markers. Arch Pathol Lab Med. 1989;
113:121-4.
Nicholson
AG, Magkou C, Snead D, Vohra HA, Sheppard MN, Goldstraw P, Beddow E, Hansell
DM, Travis WD, Corrin B.
Unusual
sclerosing haemangiomas and sclerosing haemangioma-like lesions, and the
value of TTF-1 in making the diagnosis. Histopathology. 2002;
41:404-13.
Rodriguez-Soto
J, Colby TV, Rouse RV.
A
critical examination of the immunophenotype of pulmonary sclerosing
hemangioma. Am J Surg Pathol. 2000; 24:442-50
Illei
PB, Rosai J, Klimstra DS..
Expression
of thyroid transcription factor-1 and other markers in sclerosing hemangioma
of the lung. Arch Pathol Lab Med. 2001; 125:1335-9.
Chan
KW, Gibbs AR, Lo WS, Newman GR.
Benign
sclerosing pneumocytoma of lung (sclerosing haemangioma). Thorax.
1982; 37:404-12
Heikkila
P, Salminen US.
Papillary
pneumocytoma of the lung. An immunohistochemical and electron microscopic
study. Pathol Res Pract. 1994; 190:194-200.
Kay
S, Still WJ, Borochovitz D.
Sclerosing hemangioma of the lung: an endothelial or epithelial neoplasm?
Hum
Pathol. 1977; 8:468-74
Katzenstein
AL, Weise DL, Fulling K, Battifora H..
So-called
sclerosing hemangioma of the lung. Evidence for mesothelial origin. Am
J Surg Pathol. 1983; 7:3-14.
Niho
S, Suzuki K, Yokose T, Kodama T, Nishiwaki Y, Esumi H.
Monoclonality of both pale cells and cuboidal cells of
sclerosing hemangioma of the lung. Am J Pathol. 1998; 152:1065-9.
Mikuz
G, Szinicz G, Fischer H.
Sclerosing
angioma of the lung. Case report and electron microscope investigation.
Virchows Arch A Pathol Anat Histol. 1979; 385:93-101.